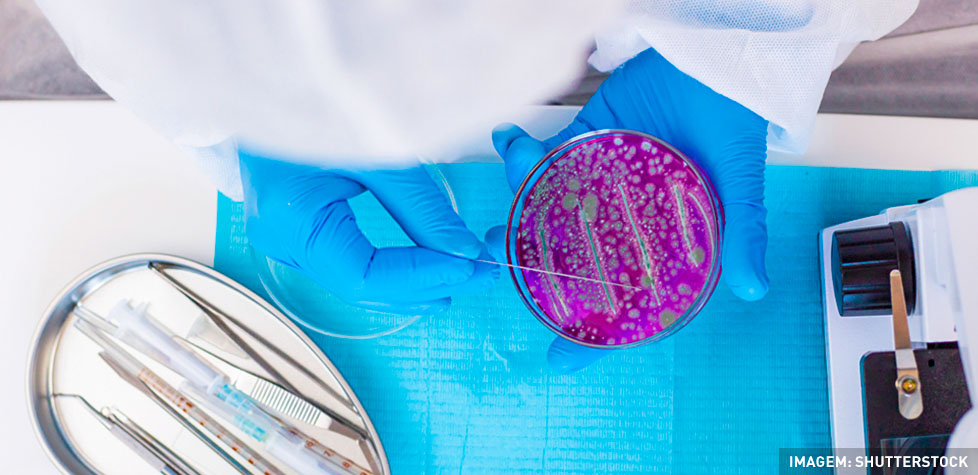

A determinação de endotoxinas bacterianas em produtos para a saúde
Redação
As endotoxinas são os componentes de lipopolissacarídeo (LPS) de peso molecular da parede celular externa de bactérias Gram-negativas, que podem induzir febre, meningite e uma rápida queda na pressão arterial, se forem introduzidas na corrente sanguínea ou em alguns outros tecidos do corpo. Os processos de esterilização inativam os microrganismos nos produtos ou dentro deles, mas geralmente não inativam a endotoxina nos produtos. Com processos controlados, a contaminação por endotoxina pode ser evitada. Há critérios normativos a serem aplicados na determinação de endotoxinas bacterianas em produtos para saúde, componentes ou matérias-primas, utilizando métodos de teste de endotoxinas bacterianas (BET), com reagentes de lisado de amebócitos.
Da Redação –
O teste de endotoxina bacteriana (bacterial endotoxin testing - BET) é um procedimento crítico que detecta e quantifica a contaminação por bactérias pirogênicas Gram-negativas em produtos farmacêuticos, injetáveis e dispositivos médicos que entram em contato com os sistemas cardiovascular e linfático. Utilizando principalmente testes de lisado de amebócitos de Limulus (LAL) — gel-coagulante, cromogênico ou turbidimétrico — garante a segurança ao aderir a limites regulatórios rigorosos, geralmente em um a quatro dias.
Os parâmetros críticos de teste incluem as instruções do fabricante do lisado devem ser consultadas quanto às temperaturas adequadas. A incubação para a metodologia BET é normalmente realizada a 37°C ± 1 °C.
As instruções do fabricante do lisado devem ser consultadas quanto aos intervalos de tempo para adição de reagentes e incubação. O tempo de incubação para a metodologia BET de coágulo em gel é normalmente de (60 ± 2) min. Para métodos cinéticos, o tempo de incubação varia de acordo com as condições do teste.
As instruções do fabrica...